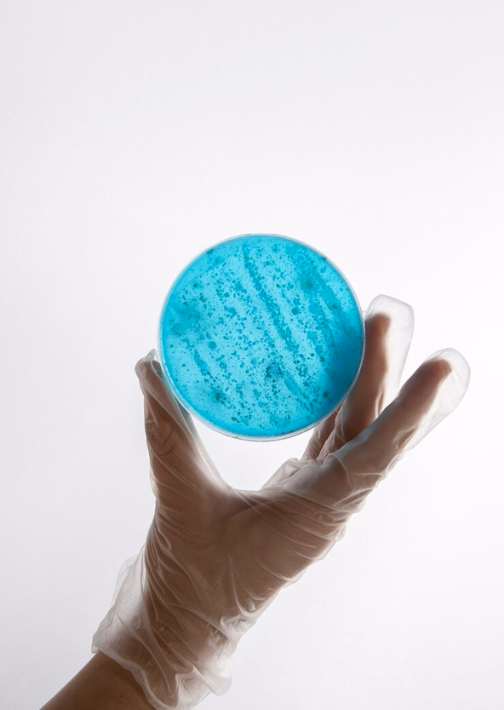

لا، باستخدام تقنية التزجيج الحديثة، يتم الحفاظ على جودة الأجنة بدرجة عالية جدًا. بعد الذوبان، تُظهر معظم الأجنة المجمدة معدلات بقاء عالية وفرص حمل مماثلة للأجنة الطازجة.
تجميد الأجنة هو إجراء حديث يُستخدم في مجال علاج الخصوبة، يتم فيه حفظ الأجنة الناتجة عن الإخصاب في المختبر (IVF) بدرجات حرارة منخفضة جدًا (تحت الصفر)، لاستخدامها لاحقًا في محاولات الحمل المستقبلية. تُعد تركيا من الوجهات الرائدة في هذا المجال، حيث توفر مراكز الخصوبة المتخصصة تقنيات تجميد حديثة (مثل تقنية التزجيج) تضمن بقاء الأجنة بحالة ممتازة بعد الذوبان.
يُستخدم تجميد الأجنة لأسباب عديدة، منها:
ما يميز تركيا في هذا المجال هو توفر تقنيات متطورة، طواقم طبية خبيرة، وتكاليف أقل مقارنة بالعديد من الدول الغربية، مع الالتزام بمعايير الجودة والأمان الدولية.
تختلف التكلفة حسب المركز والحالة، ولكن بشكل عام، تتراوح بين:
1500 – 3000 دولار أمريكي
وهذا السعر يشمل عادة:

لا، باستخدام تقنية التزجيج الحديثة، يتم الحفاظ على جودة الأجنة بدرجة عالية جدًا. بعد الذوبان، تُظهر معظم الأجنة المجمدة معدلات بقاء عالية وفرص حمل مماثلة للأجنة الطازجة.
يمكن حفظ الأجنة لمدة 5 سنوات قابلة للتجديد، بشرط تقديم موافقة رسمية من الزوجين سنويًا. ويمكن تمديد هذه المدة إذا كانت هناك أسباب طبية أو قانونية مبررة.
نعم، يتم استخدام الأجنة المجمدة في دورات لاحقة دون الحاجة لإعادة تحفيز المبيض أو جمع بويضات جديدة، مما يوفر الوقت والتكلفة ويقلل من الإجهاد الجسدي.
تجميد الأجنة يتم بعد تخصيب البويضات بالحيوانات المنوية، بينما يتم تجميد البويضات غير المخصبة. فرص النجاح عادةً أعلى مع تجميد الأجنة نظرًا لثباتها البيولوجي الأفضل.
كنت أرغب في تأجيل الحمل بسبب ظروف العمل، وقررت تجميد الأجنة في تركيا مع Surgery Turkiye. التجربة كانت مريحة جدًا، والفريق الطبي كان متعاونًا وشرح لي كل التفاصيل. أشعر الآن براحة نفسية لأنني أملك فرصة مستقبلية للحمل في الوقت المناسب.
بعد عدة محاولات غير ناجحة للحمل، نصحني الطبيب بتجميد الأجنة لاستخدامها لاحقًا في دورة منظمة. في تركيا، كانت العناية ممتازة، والتكلفة أقل بكثير من العيادات في بلدي. الأهم أنني أشعر بالأمل والثقة بالمستقبل.
كنت قلقة من تأخر الحمل بعد الأربعين، فقررت تجميد الأجنة كخطة بديلة. اخترت تركيا بسبب سمعتها الجيدة وتكلفتها المناسبة، ولم أندم. الإجراء كان بسيطًا والنتائج فاقت توقعاتي من حيث جودة الأجنة المجمدة.

تبدأ العملية باستخدام أدوية لتحفيز إنتاج عدة بويضات بدلاً من بويضة واحدة خلال الدورة الشهرية.

تُخصب البويضات بالحيوانات المنوية (من الزوج غالبًا) في المختبر لتكوين الأجنة.

تُجمَّد الأجنة عالية الجودة باستخدام تقنية التزجيج التي تمنع تكوّن البلورات داخل الخلايا وتحافظ على بنيتها.
تجميد الأجنة يتيح للنساء فرصة الحفاظ على خصوبتهن، خاصة قبل الخضوع لعلاجات طبية قد تؤثر على القدرة على الحمل، مثل العلاج الكيميائي أو جراحات المبيض.
تعتمد مراكز الخصوبة في تركيا على أحدث تقنيات التزجيج التي تضمن بقاء الأجنة في حالة ممتازة لفترات طويلة، مما يزيد من فرص الحمل الناجح عند استخدامها.
يمكن استخدام الأجنة المجمدة في دورات لاحقة دون الحاجة لتحفيز المبايض أو سحب بويضات جديدة، مما يقلل من التعب والتكاليف.
تركيا تقدم خدمات طبية متقدمة بأسعار منافسة، مما يجعل تجميد الأجنة خيارًا ميسور التكلفة للعديد من الأزواج.


تجميد الأجنة باستخدام تقنيات التزجيج الحديثة في تركيا يحقق نتائج ممتازة في الحفاظ على جودة الأجنة لفترات طويلة. بعد الذوبان، تتمتع الأجنة بنسبة عالية من البقاء على قيد الحياة، مما يزيد فرص الحمل الناجح في المحاولات اللاحقة.
تُظهر الدراسات السريرية أن معدلات الحمل باستخدام الأجنة المجمدة لا تختلف كثيرًا عن الأجنة الطازجة، خاصة عند إجراء التلقيح الصناعي (IVF) في مراكز ذات خبرة عالية مثل تلك الموجودة في تركيا.
علاوة على ذلك، يمكن للمرضى الاعتماد على استرجاع الأجنة المجمدة في وقت مناسب لهم، مما يمنحهم مرونة كبيرة في التخطيط للحمل والتقليل من التوتر النفسي المرتبط بالعقم.